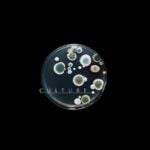

Winston-Salem Street School







Pleasants Provisions

The Hideout Men’s Salon


Top of Fourth ~ Courtyard Rooftop Lounge



Cotton Street Apparel

West End Barber & Shave




Piedmont Opera

Leadership Winston-Salem


The Enrichment Center


Bread of Heaven ~ Old Salem Tavern




Tuscani by Sage & Salt

Big Brothers ~ Big Sisters Services Inc.

Elite Movement Physical Therapy & Personal Training

Low Five Analog Archive

Grandpa Joe’s Slaberia



Good Company Salon ~ WS

Winston-Salem Wellness Collective

Piercings By Molly

Insight Human Services

Courtyard Winston-Salem Downtown


Oasis at The Mill

Emerald Edge Hair Salon



Boston-Thurmond United Outreach Center

Winston-Salem Rescue Mission

Bobby Boy Bakeshop

Bella & James Children’s Boutique



Contempo Chocolates



4th Street Brow & Parlor Studio

Foundations Early Learning Center

The Nash Museum

Salem Baptist Christian School

Whole Skin Studio

West End Hair Studio

Humble Hands Massage Therapy

Hello Sugar ~ WS

Boutique Wellness Rejuvenation Center

Blowouts & Bubbles ~ WS


The Dutch Light

Pure Sweat Winston-Salem

Hotel Indigo
104 W. Fourth Street, Winston-Salem, NC 27101
Completed in 2019. This 75 room hotel was completed by Mayfair Street Partners. This historic 49,000 SF art deco style building (built in 1928) was renovated for an estimated $18M.

104 W. Fourth Street, Winston-Salem, NC 27101
Completed in 2019. This 75 room hotel was completed by Mayfair Street Partners. This historic 49,000 SF art deco style building (built in 1928) was renovated for an estimated $18M.
Roar Entertainment Complex
633 N. Liberty Street, Winston-Salem, NC 27101
Dining and Entertainment Destination. Completed in 2022 by Mayfair Development Partners.
Bowling Alley, Simulators (Golf and other). Food Hall, Restaurants. Rooftop Bar.
https://www.wxii12.com/article/winston-salem-twin-city-motor-food-hall-bowling-golf-center/35121773#

633 N. Liberty Street, Winston-Salem, NC 27101
Dining and Entertainment Destination. Completed in 2022 by Mayfair Development Partners.
Bowling Alley, Simulators (Golf and other). Food Hall, Restaurants. Rooftop Bar.
https://www.wxii12.com/article/winston-salem-twin-city-motor-food-hall-bowling-golf-center/35121773#

Legal Leaf ~ WS

Goat Feathers Antiques & Collectibles

Bagner & Alexa’s Downtown Cafe


Studio 2 Bead Shop

Lizzie’s All Natural Products

Hook and Ladder Party Pumper

Majestic Pour


Palm Green Tattoo


Sally Gupton Photography

Sacred Harmony: Center for Wellbeing

Lulu Gal Jewelry


DABL Salon and Boutique



Black Dahlia Studio & Head Spa


Monograms Etc.

Big Winston Stockhouse




GreeNest of Winston-Salem


Dress for Success ~ Winston Salem


The Little Theatre of Winston-Salem

Adrian’s Hair Sculpture


That Place in the West End

The Remedy Cafe & Bar


Eight Points Muay Thai

Bellissima Bridal Shop


Oriental Treasures

The Eclectible Shop


Louie & Honey’s Kitchen


Contempo Concepts

West End Cabinet Company

The Boho Depot

Village Frame Shop

Smoke City Meats

Sea Products, Inc.

Dream Kreams ~ Artisanal Creamery

Manolo’s Boutique Wines & Bistro



Dark Roots Tattoo Co.

Elizabeth’s at Hanes Park

Green Bee Floral Designs


Fourth Street Art & Frame

Cookie’s Shabbytiques

Spotted Cow Steakhouse


Cam’s Coffee Co @ Kaleideum

CMPND


Touch of Art ~ Barbershop + Hair Studio

The Goddess Experience Boudoir Studio

Sir Speedy Print, Signs, Marketing

Wine & Design ~ WS

Winston-Salem Symphony Association





RIA Solutions Group

Lighthouse Small Business Solutions



North Star LGBTQ – Community Center

Flywheel WS Co-Working Meeting Space


Winston Salem Theatre Alliance



Small Footprint, Inc.


Level Up Solutions


Retroid Games

Cheryl Powell Art Studio

Sage & Salt Bistro


Synergy Winston-Salem

Seventh Key Tattoo Studio

SE Logo Wear Inc.



CasaShanti on Trade

Kin & Cottage

Off The Rack


Top Leaf Cigar Lounge



The Dose Artist Collective




Hungry Palate Bar & Grill




Founders at the Shaffner Inn ~ Event Venue

In Love Tattoo

STEM Beverage & Supply




Evelyn Rose Boutique

Xpresscreen, Inc.

Smoke Rings Smoke Shop



Cheesecakes by Alex Twin City

BYGood Coffee

Muddy Creek Cafe & Listening Room





F45 Training Winston-Salem



Celestial Wellness

Theresa Duncan’s Fashion and Variety Store

Camel City Playhouse


FIT-4-Life Personal Training Studio

Design+ by Cassandra Michelle

Hempress Farms LLC

Salem Organic Supply

Guru Convenience

A Child’s World learning Center

UNCSA Stevens Center

Pink Rhino Beauty Parlor





Flow Automotive Companies



Sutler’s Spirits Co

Radar Brewing Company

MIXXER

Quality Glass Engraving

Piedmont Federal Savings Bank


Salem Funeral and Cremation Services

Sophisticated Florals by Stephanie

The Snob Shop

Major Tomms Oddities & Vintage

North Trade Street Arts Center

Tattoo Revival

Eyewear Unlimited

Wood & Thread Boutique


Ember Audio + Design


Henry F Shaffner House Bed & Breakfast

Summit Street Bed & Breakfast Inns

Yamas Mediterranean Street Food

Cugino Forno Pizzeria

Sir Winston Wine Loft & Restaurant



Cibo Trattoria Italian Cuisine


Young Cardinal Cafe and Co.

Rena Marie’s Coffees & Bubble Tea

RideUnited ~ Cyclebar

Twin City Fitness & Personal Training


Arts Council Gift Shop

Sawtooth School for Visual Art Retail Shop

Hampton Inn & Suites Winston-Salem Downtown

4th Street Parking Deck (@ Poplar)

Link Innovation Quarter

Footnote Coffee & Cocktails


The Porch Kitchen & Cantina

Xcaret Mexican Grill & Cantina

Heyday Guitars

Bookmarks


Fair Witness Fancy Drinks

Joymongers Barrel Hall

Incendiary Brewery



Carolina’s Vineyards & Hops ~ (Private Events Only)

Lasso Gaucho Brazilian Steakhouse

Truliant Federal Credit Union

Cherry Street Parking Deck

2nd Chestnut Street Lot


Forsyth County Government Center


6th-Cherry/Trade Parking Deck


Cherry/Marshall Parking Deck





Center City West Parking Deck
Dogwood Hops and Crops

Wise Man Brewing

The Katharine Brasserie & Bar



Intersection Gallery

Unleashed Art Center

Old North State Tattoo Co.

Paintings by Louis-Guidetti

Alan Calhoun Photography

John Stevens Calligraphy

Diane Demers-Smith

Mast General Store



MUSE Winston Salem


Liberty Plaza Parking Deck

Allegacy Federal Credit Union

Design Archives

Trouvaille Home

Smokey Shay’s Tobacco

Associated Artists

Body and Soul

Press 53

The B String



Foundations Early Learning Center



Goler Memorial African Methodist Episcopal Zion Church

United Metropolitan Missionary Baptist Church

St. Paul’s Episcopal Church


The Millennium Center

Center City US Post Office

Truist Drive Thru Branch

WS Employees Federal Credit Union


Aaron Elliot Locksmith



Lefkowitz & K.I. Sunder Tailor

Shell Gas & Convenience

4 Brothers Convenience Store


Centenary United Methodist Church

First Presbyterian Church

Lloyd Presbyterian Church

Augsburg Lutheran Church

Our Lady of Fatima Chapel


Camel City BBQ Factory





Recreation Billiards


Second & Green Tavern

Fiddlin’ Fish Brew Company

Broad Branch Distillery



Mission Pizza Napoletana





Finnigan’s Wake Irish Pub

The Famous Toastery




Di Liso’s Italian Restarant


Washington Perk & Provisions




Quanto Basta Italian Eatery & Wine Bar

Mozelle’s Fresh Bistro

Old 4th Street Filling Station

Thai Harmony and Sushi Bar





Foothills Brewing Company

Jack Jennings Metalsmith

Piedmont Craftsmen

Red Dog Gallery

The Horton Museum Center Store

Visual Index

W-S Rescue Mission Thrift Shop

Keona’s Boutique & Beauty

Miksch House & Shop

Tattoo Archive

Piedmont Music Center

Imagine Flowers

Apple Coin & Pawn Shop

Artworks Gallery

Clean Daze

Gateway Gallery

The Historic Brookstown Inn



The Fairfield Inn & Suites

Forsyth Technical Community College


Sawtooth School For Visual Art

University of North Carolina School of The Arts

Winston Salem State University

City Beverage

William G. White Branch of the YMCA

Aperture Cinema

Steven’s Center of UNCSA

Milton Rhodes Center for Arts/ Hanesbrands Theatre

Old Salem Museums




Purrfect Cut Barber Shop

Sixth Sense Health & Wellness

The RETREAT Hair and Nail Studio



Douglass Battery & Auto Care